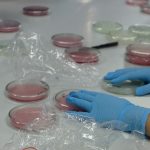

คณะเทคโนโลยีและสิ่งแวดล้อม มหาวิทยาลัยสงขลานครินทร์ วิทยาเขตภูเก็ต จัดโครงการอบรมเชิงปฏิบัติการ “TE Envi Guardians” สำหรับนักเรียนชั้นมัธยมศึกษาตอนต้น โรงเรียนหาดใหญ่วิทยาลัย 2 จังหวัดสงขลา ระหว่างวันที่ 11–12 สิงหาคม 2568 ณ อาคารเรียนรวมและปฏิบัติการกลาง (อาคาร 6) มหาวิทยาลัยสงขลานครินทร์ วิทยาเขตภูเก็ต ภายในโครงการประกอบด้วยการบรรยายและกิจกรรมเชิงปฏิบัติการที่มุ่งเน้นการเรียนรู้ด้านสิ่งแวดล้อม โดยมีเนื้อหาสำคัญ ได้แก่
๐ การบรรยายหัวข้อ “คุณภาพน้ำต่อสิ่งแวดล้อมและสุขภาพมนุษย์” พร้อมการเรียนรู้การเก็บตัวอย่างน้ำและการวิเคราะห์คุณภาพน้ำ โดยผู้ช่วยศาสตราจารย์ ดร.ดนัย ทิพย์มณี
๐ การอบรมเชิงปฏิบัติการหัวข้อ “การวิเคราะห์จุลินทรีย์ในน้ำ” โดย ดร.สรณ์สิริ พงศ์ภัทรวัต
๐ การอบรมเชิงปฏิบัติการหัวข้อ “การวิเคราะห์ออกซิเจนในน้ำ” และ “การวิเคราะห์แอมโมเนียในน้ำ” โดยผู้ช่วยศาสตราจารย์ ดร.ธนกร จิวรุ่งเรืองกุล
๐ การอบรมเชิงปฏิบัติการหัวข้อ “การคำนวณผลการวิเคราะห์ การจัดทำรายงานผล และการนำเสนอ” โดยผู้ช่วยศาสตราจารย์ ดร.ดนัย ทิพย์มณี
โครงการนี้มีนักเรียนระดับชั้นมัธยมศึกษาปีที่ 3 โครงการห้องเรียนพิเศษ SMP โรงเรียนหาดใหญ่วิทยาลัย 2 จังหวัดสงขลา จำนวน 58 คน พร้อมด้วยครูผู้ควบคุม 6 คน เข้าร่วมอย่างพร้อมเพรียง

Leave a Reply